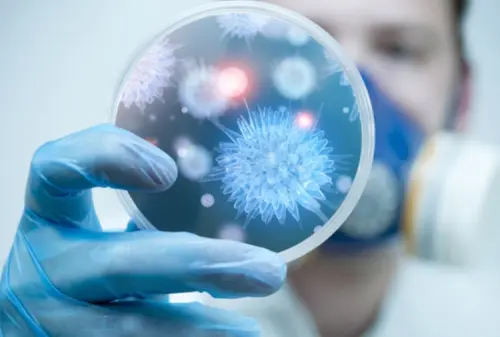
TITOLO

Batteri resistenti agli antibiotici minano salute neonati
di Redazione

In Italia si usano troppi antibiotici. Si usano anche quando non servono. Si tratta di una pessima e deleteria abitudine, visto che favorisce il rafforzamento dei batteri. Ogni anno muoiono molti neonati a causa di infezioni batteriche. Tutto ciò potrebbe essere evitato se solo non si facesse un uso smodato degli antibiotici. Questi, infatti, rendono più forti i batteri. Ogni anno le infezioni uccidono molti neonati perché le terapie con gli antibiotici non producono effetti. Ciò è a dir poco inquietante.
Rafforzamento dei batteri è una seria insidia
Gli esperti della Società Italiana di Neonatologia hanno detto che il rafforzamento dei batteri costituisce una seria insidia per la salute dei neonati. Da un lato, dunque, è necessario che le aziende farmaceutiche producano medicinali efficaci; dall'altro bisogna che le persone assumano antibiotici in modo responsabile. Il presidente della Sin, Mauro Stronati, ha dichiarato:"La storia della scoperta di nuove classi di antibiotici ci insegna che l'emergere di resistenze avviene naturalmente, non appena l'antibiotico viene utilizzato. Il quadro che emerge è quello di un mondo in cui l'arsenale per combattere i microrganismi è sempre più povero di mezzi. E' necessaria una presa di coscienza individuale e collettiva sul fenomeno, ma principalmente l'adozione di un protocollo rigoroso all'interno degli ospedali e nelle cure che prevedono l'impiego di antibiotici".
Non assumere antibiotici quando non serve
In Italia i neonati corrono molti rischi perché, negli ultimi decenni, è aumentato moltissimo il ricorso agli antibiotici. Tali farmaci si usano spesso anche quando non serve e ciò non fa altro che fortificare i batteri. Solo quattro nazioni (Grecia, Francia, Lussemburgo e Belgio) sono davanti al Belpaese per uso quotidiano di antibiotici. I neonatologi italiani sostengono che la problematica della resistenza dei batteri agli antibiotici va risolta su due fronti: locale e globale. Innanzitutto i medici non devono prescrivere sempre gli antibiotici e i Governi devono incentivare le aziende farmaceutiche a creare medicinali nuovi ed efficaci. I più vulnerabili ai batteri resistenti agli antibiotici sono dunque i neonati. E' bene fronteggiare la problematica per evitare altri decessi di piccoli innocenti. Gli stessi genitori devono ricordare di usare gli antibiotici solo quando serve, non, ad esempio, quando i figli hanno una lieve febbre. Gli antibiotici sono fondamentali, è vero, per contrastare le infezioni gravi ma negli ultimi anni sempre più persone ne fanno un uso indiscriminato.Evitare 'era post antibiotici': semplici infezioni torneranno ad uccidere?
Se ne sono dette tante, negli ultimi tempi, sui batteri resistenti agli antibiotici e se ne diranno altre. C'è chi, usando toni sensazionalistici, preconizza una prossima apocalisse e chi ritiene che una soluzione a super batteri esiste. Secondo un rapporto britannico, entro il 2050 uccideranno più i batteri super resistenti che il cancro. Le infezioni potenti e resistenti qualsiasi antibiotico provocheranno 10 milioni di morti, praticamente una persona ogni 10 secondi. Si rischia una vera strage di innocenti per colpa di comportamenti sbagliati. Il rapporto è stato stilato al termine di un'indagine voluta due anni fa dal premier David Cameron. L'autore della ricerca, O'Neill, ha dichiarato che tutti i Governi devono intervenire al più presto per evitare un ritorno al Medioevo. Tutti devono fare la loro parte: sia gli esecutivi nazionali, stanziando fondi necessari alla creazione di antibiotici potenzi, che le case farmaceutiche e i privati. Questi ultimi devono capire che gli antibiotici non vanno assunti sempre, ma solo dietro raccomandazione del medico. L'uso degli antibiotici va ridotto anche nell'ambito della zootecnia. O'Neill ha esortato la gente a non considerare gli antibiotici come caramelle. Dall'inizio della ricerca fino alla metà del 2014 sono decedute oltre un milione di persone a causa di malattie dovute a batteri resistenti agli antibiotici. La stessa Oms, l'anno scorso, ha messo in guardia sui rischi derivanti dall'uso smodato degli antibiotici, prospettando una sorta di 'era post-antibiotici' in cui le malattie che si credevano ormai eliminate torneranno ad uccidere. Se il problema non verrà fronteggiato subito, moltissime persone verranno uccise dai batteri super resistenti, soprattutto in Asia e in Africa, ma anche in Italia che, come detto prima, è una delle nazioni dove proliferano molti batteri resistenti agli antibiotici. Bisogna evitare assolutamente di ritrovarci in un'era in cui quei farmaci che hanno salvato molte vite si riveleranno inidonei a contrastare anche banali infezioni. Riflettiamo ed interveniamo al più presto per consegnare un mondo migliore, non peggiore, alle future generazioni.Articolo Precedente
Charlie Sheen parla della sua sieropositività al The Graham Norton Show
Articolo Successivo
Crea app a 9 anni: Anvitha Vijay stupisce anche Tim Cook



